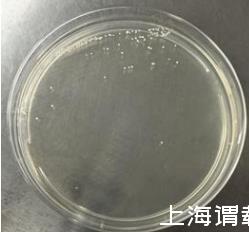

合作客戶/
拜耳公司 |
同濟大學 |
聯合大學 |
美國保潔 |
美國強生 |
瑞士羅氏 |
相關新聞Info
推薦新聞Info
-
> 基于表面光散射法的棕櫚酸甲酯/乙酯高溫表面張力與黏度測量(三)
> 基于表面光散射法的棕櫚酸甲酯/乙酯高溫表面張力與黏度測量(二)
> 基于表面光散射法的棕櫚酸甲酯/乙酯高溫表面張力與黏度測量(一)
> 不同礦漿濃度、粒度、伴生礦物、捕收劑和起泡劑對礦漿表面張力的影響(三)
> 不同礦漿濃度、粒度、伴生礦物、捕收劑和起泡劑對礦漿表面張力的影響(二)
> 不同礦漿濃度、粒度、伴生礦物、捕收劑和起泡劑對礦漿表面張力的影響(一)
> 長慶油田隴東地區的CQZP-1助排劑表/界面張力測量及現場應用(三)
> 長慶油田隴東地區的CQZP-1助排劑表/界面張力測量及現場應用(二)
> 長慶油田隴東地區的CQZP-1助排劑表/界面張力測量及現場應用(一)
> 液膜斷裂點與電壓最大值在表面張力測量中的對比研究(二)
混合型生物洗油菌發酵上清液的表面張力值測定(二)
來源:東北石油大學三亞海洋油氣研究院 黑龍江省科學院微生物研究所 瀏覽 978 次 發布時間:2025-01-03
本實施方式中的解淀粉芽孢桿菌(Bacillus amyloliquefaciens)ZZ-11于2023年9月,從哈爾濱市的農作物根際土壤中分離純化獲得。
①分離方法采用梯度稀釋法:去除表土,取5~20cm深處的土樣幾十克石油污染土壤,盛入事先滅過菌的防水紙袋內;取10g石油污染土壤在90mL無菌水三角瓶中振搖(搖床振搖30min靜置),然后取5mL上清液接種于95mL無菌的牛肉膏液體培養基中,在溫度為30℃、搖床轉速為150r/min的恒溫搖床培養2d;之后取土樣液逐級稀釋至10-6。挑取單菌落接種LB培養基平板中涂勻?于28℃恒溫培養。
②?純化方法?:反復劃線培養,直至確認同一平板中菌落的形態和大小都相同,得到純化后的單菌株ZZ-11。
③革蘭氏染色:挑取單菌落進行革蘭氏染色并鏡檢,鑒別細菌的類型。
④16s測序鑒定,該菌株16S rDNA的核苷酸序列如SEQ ID NO:1所示。
該菌株16S rDNA序列比對(NCBI數據庫)與芽孢桿菌屬(Bacillus)的解淀粉芽孢桿菌(Bacillus amyloliquefaciens)有極高的同源性,同源性為98%以上,并結合該菌株的革蘭氏染色(如圖1所示)和鏡檢結果認定其為解淀粉芽孢桿菌,命名為解淀粉芽孢桿菌(Bacillus amyloliquefaciens)ZZ-11。

圖1是解淀粉芽孢桿菌(Bacillus amyloliquefaciens)ZZ-11革蘭氏染色觀察圖;
本實施方式解淀粉芽孢桿菌(Bacillus amyloliquefaciens
)ZZ-11可采用LB培養基培養,培養溫度為28~30℃。本實施方式解淀粉芽孢桿菌(Bacillus amyloliquefaciens)ZZ-11在LB固體培養基上菌落形態為污白色圓形或不規則菌落,表面粗糙,粘稠(如圖2所示),經革蘭氏染色為革蘭氏陽性菌。
圖2是解淀粉芽孢桿菌(Bacillus amyloliquefaciens)ZZ-11平板培養菌落觀察圖;
具體實施方式二:本實施方式一種可用于洗油的微生物,其為膠凍樣芽孢桿菌(Bacillus mucilaginosus)ZZ-8,保藏在中國微生物菌種保藏管理委員會普通微生物中心,保藏號為CGMCC N0.30789。
本實施方式中的膠凍樣芽孢桿菌(Bacillus mucilaginosus)ZZ-8于2023年9月,從哈爾濱市的農作物根際土壤中分離純化獲得。
分離方法采用梯度稀釋法:去除表土,取5~20cm深處的土樣幾十克石油污染土壤,盛入事先滅過菌的防水紙袋內;取10g石油污染土壤在90mL無菌水三角瓶中振搖(搖床振搖30min靜置),然后取5mL上清液接種于95mL無菌的牛肉膏液體培養基中,在溫度為30℃、搖床轉速為150r/min的恒溫搖床培養2d;之后取土樣液逐級稀釋至10-6。挑取單菌落接種LB培養基平板中涂勻?于28℃恒溫培養。
②?純化方法?:反復劃線培養,直至確認同一平板中菌落的形態和大小都相同,得到純化后的單菌株ZZ-8。
③革蘭氏染色:挑取單菌落進行革蘭氏染色并鏡檢,鑒別細菌的類型。
④16s測序鑒定,該菌株16S rDNA的核苷酸序列如SEQ ID NO:2所示。
該菌株16S rDNA序列比對(NCBI數據庫)與芽孢桿菌屬(Bacillus)的膠凍樣芽孢桿菌(Bacillus mucilaginosus
)有極高的同源性,同源性為98%以上,并結合該菌株的革蘭氏染色(如圖3所示)和鏡檢結果認定其為膠凍樣芽孢桿菌,命名為膠凍樣芽孢桿菌(Bacillus mucilaginosus)ZZ-8。

圖3是膠凍樣芽孢桿菌(Bacillus mucilaginosus)ZZ-8革蘭氏染色觀察圖;
本實施方式膠凍樣芽孢桿菌(Bacillus mucilaginosus)ZZ-8可采用LB培養基培養,培養溫度為28~30℃。本實施方式膠凍樣芽孢桿菌(Bacillus mucilaginosus
)ZZ-8在LB固體培養基上菌落形態為無色透明,有光澤,表面光滑,圓形隆起,粘稠、邊緣整齊(如圖4所示),經革蘭氏染色為革蘭氏陰性菌。
圖4是膠凍樣芽孢桿菌(Bacillus mucilaginosus)ZZ-8平板培養菌落觀察圖;
具體實施方式三:本實施方式用于微生物洗油的混合菌劑由解淀粉芽孢桿菌(Bacillus amyloliquefaciens)ZZ-11和膠凍樣芽孢桿菌(Bacillus mucilaginosus)ZZ-8組成。
具體實施方式四:本實施方式與具體實施方式三的不同點在于:混合菌劑中解淀粉芽孢桿菌(Bacillus amyloliquefaciens)ZZ-11與膠凍樣芽孢桿菌(Bacillusmucilaginosus)ZZ-8的數量比為(108~109):(107~108)。其它與具體實施方式三相同。
具體實施方式五:本實施方式與具體實施方式三或四的不同點在于:混合菌劑中菌落總濃度為108~109cfu/mL。其它與具體實施方式三或四相同。
實施例1
乳化性能測試:
將解淀粉芽孢桿菌(Bacillus amyloliquefaciens)ZZ-11、膠凍樣芽孢桿菌(Bacillus mucilaginosus)ZZ-8、混合菌劑(解淀粉芽孢桿菌(Bacillusamyloliquefaciens
)ZZ-11和膠凍樣芽孢桿菌(Bacillus mucilaginosus)ZZ-8按1:1數量比混合)分別接種于LB液體培養基中,在28~30℃條件下振蕩培養發酵,直至發酵液中菌落濃度達到108
~109cfu/mL。
在25ml具塞量筒中分別加入上述5ml發酵液和5ml原油,隨后置于45℃恒溫箱內20min。密閉后將具塞量筒劇烈振蕩5min,然后再次置于45℃恒溫箱中靜置,同時開始計時,每隔10min記錄試管中分離出水的體積,計算析水率。重復實驗三次。其公式為Ed=Vw/V,式中,Ed為析水率;Vw為析水量,mL;V為總體水相體積,mL。
利用析水率評價生物表面活性劑作用原油后形成水包油型乳狀液的穩定性,析水率數值越小,說明乳狀液越穩定,體系的乳化性能越強。從圖中可以看出隨著時間的延長各組析水率不斷增加,一段時間后ZZ-11、ZZ-8、混合菌劑的析水率穩定,分別為47%、44%和16%(如圖5所示)。

圖5是實施例1乳化性能測試中ZZ-11、ZZ-8、混合菌劑析水率曲線圖。
析水率可用于評價生物表面活性劑對原油的乳化性能,根據實驗結果可知解淀粉芽孢桿菌(Bacillus amyloliquefaciens)ZZ-11和膠凍樣芽孢桿菌(Bacillusmucilaginosus)ZZ-8發酵液均具有良好的乳化性能,混合菌劑的乳化性能更為優異和突出。










